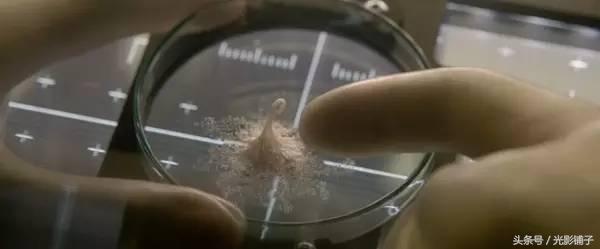
当你觉得自己智商遭到碾压时,当你在吐槽时

最近上映的科幻大片《异星觉醒》,一定程度上说扑街了。

该片可以说是脱胎于1979年的《异形》,整部电影似乎都是在它的基础上演绎。

《异形》海报
或许是因为近些年类似的电影太多,观众都麻木了,所以自从上映一来,各大电影网站的评分都开始下滑,观众由一开始的期待到最后直接变成了吐槽。

其实,静下心来想《异星觉醒》背后所传达的主题,虽然老套但是值得深思。影片的主题很明确很简单,它呈现了当人类遇见外星生物(未知事物)时的恐惧、愚蠢和不知所措。

这貌似很简单地主题,是人类在地球千万年进化过程中一直存在的问题,套用一句广告词,它”简约却不简单”。
我们都知道,人类在对待未知事物上本应该表现出一种敬畏之心,尤其像对待外星物种。
因为它们很可能是比人类更高级的物种,对人类的生存有着极大地威胁,我们必须谨慎处置才行。

但是现实是观众对本来该关心的东西视而不见,注意力都集中在电影人物的“蠢萌”上。
这主要是因为,电影中的人物在外星生物面前极为愚蠢,电影缺乏逻辑性和科学性,总之在他们眼里整部电影就是一部弱智片。
于是乎大家五花八门的吐槽层出不穷的涌现了。
我认为这种反应是对《异星觉醒》的误解,而那些吐槽表面上是在嘲笑电影人物智商的低下,实际上在嘲笑自己而不自知。
甚至可以说这种反应把你自己的智商都拉低了。

很多人可能不知道,类似电影中人物的“蠢萌”现象早在79年《异形》极其后续系列里就已经出现了,那时的观众多少也有嘲讽,但是还不是很明显。
如今快三十年过去了,没想到的是观众还是如此,而且那么的变本加厉,估计导演快要气疯了,观众的这种表现细想起来真的是细思极恐。
电影《异星觉醒》怎么说都是一部大制作,难道制作电影的那帮人真的就那么弱智?想想三十年前的《异形》,以及后来的系列电影,难道这帮人也都弱智了?弱智了近三十年?
显然不是这样!

从一方面来说电影中人物的“蠢萌”形象,都是有意为之的。
所谓的缺乏科学性、逻辑性都是为剧情需要而设定的,其意图很明显,就是为了最终把人类在遇到外星人可能出现的愚蠢状态呈现出来。
或许人类在那个时候真的就是这个样子。
类比一下,想想过去我们首次遇到某种重大灾难(比如地震)的时候,人类表现出来是多么的糟糕,多么的愚蠢?
只不过后来在经历了千百次演习后,当地震再次来临的时候,我们才能够熟练地躲避灾难。
而外星物种是我们从未遇见过的,所以凭人类以往的的经验,当我们遇到外星物种的时候的反应就应该像首次遇到地震一样,好不到哪里去。

从另一方面来说,电影中呈现的外星生物超强的进化能力和攻击能力,显然是人类不能及。
这样的设定目的在于凸显出人类的渺小,进而可以警醒人类更加认真的审慎的对待未知事物,不要盲目自大。
很久以来我们自诩为地球主宰,其实在整个宇宙中人类不过尔尔,当外星生物觉醒的时候是可以瞬间碾压人类的。
电影中外星生物凯文的觉醒,人类是起到了推波助澜的作用。
这一点在《异形》中也是如此,只不过那部影片里是宇航员无意为之,而在《异星觉醒》里宇航员有意这么做的,而这种设定更加突出了人类的愚蠢。
外星生物凯文
影片《异星觉醒》还有些情节暗示人类想扮演上帝的角色,这进一步体现了人类的自不量力。
比如黑人科学家自认为是自己让外星物种复活了,所以做了外星物种的爸爸,他用手指指凯文的画面与上帝开启人类生命的画面很相似。
但是随之我们看到了后面充满讽刺画面,外星生物凯文杀死了黑人科学家。我想这应该是对人类最大的嘲讽吧?

以上种种都说明电影是在明确的向观众呈现人类在遇见外星生物(未知事物)时的恐惧、愚蠢和不知所措,其目的在警示人类,影片的指向再简单不过。
可悲的是电影《异星觉醒》明明是在嘲笑人类的愚蠢,而观众却对此不明所以的大加吐槽,真的是更加的愚蠢。
这就好比别人骂你*逼傻**,而你却吐槽怎么会真的有这样的*逼傻**。

从《异形》开始,一些观众的表现就令人着急,如今多少年过去了还是如此,真的无知者无畏啊,这真的很悲哀!
其实说到底,人类还是很聪明,不然怎么会有如此辉煌的今天呢?但是有句话说得好你永远叫不醒一群装死的人。